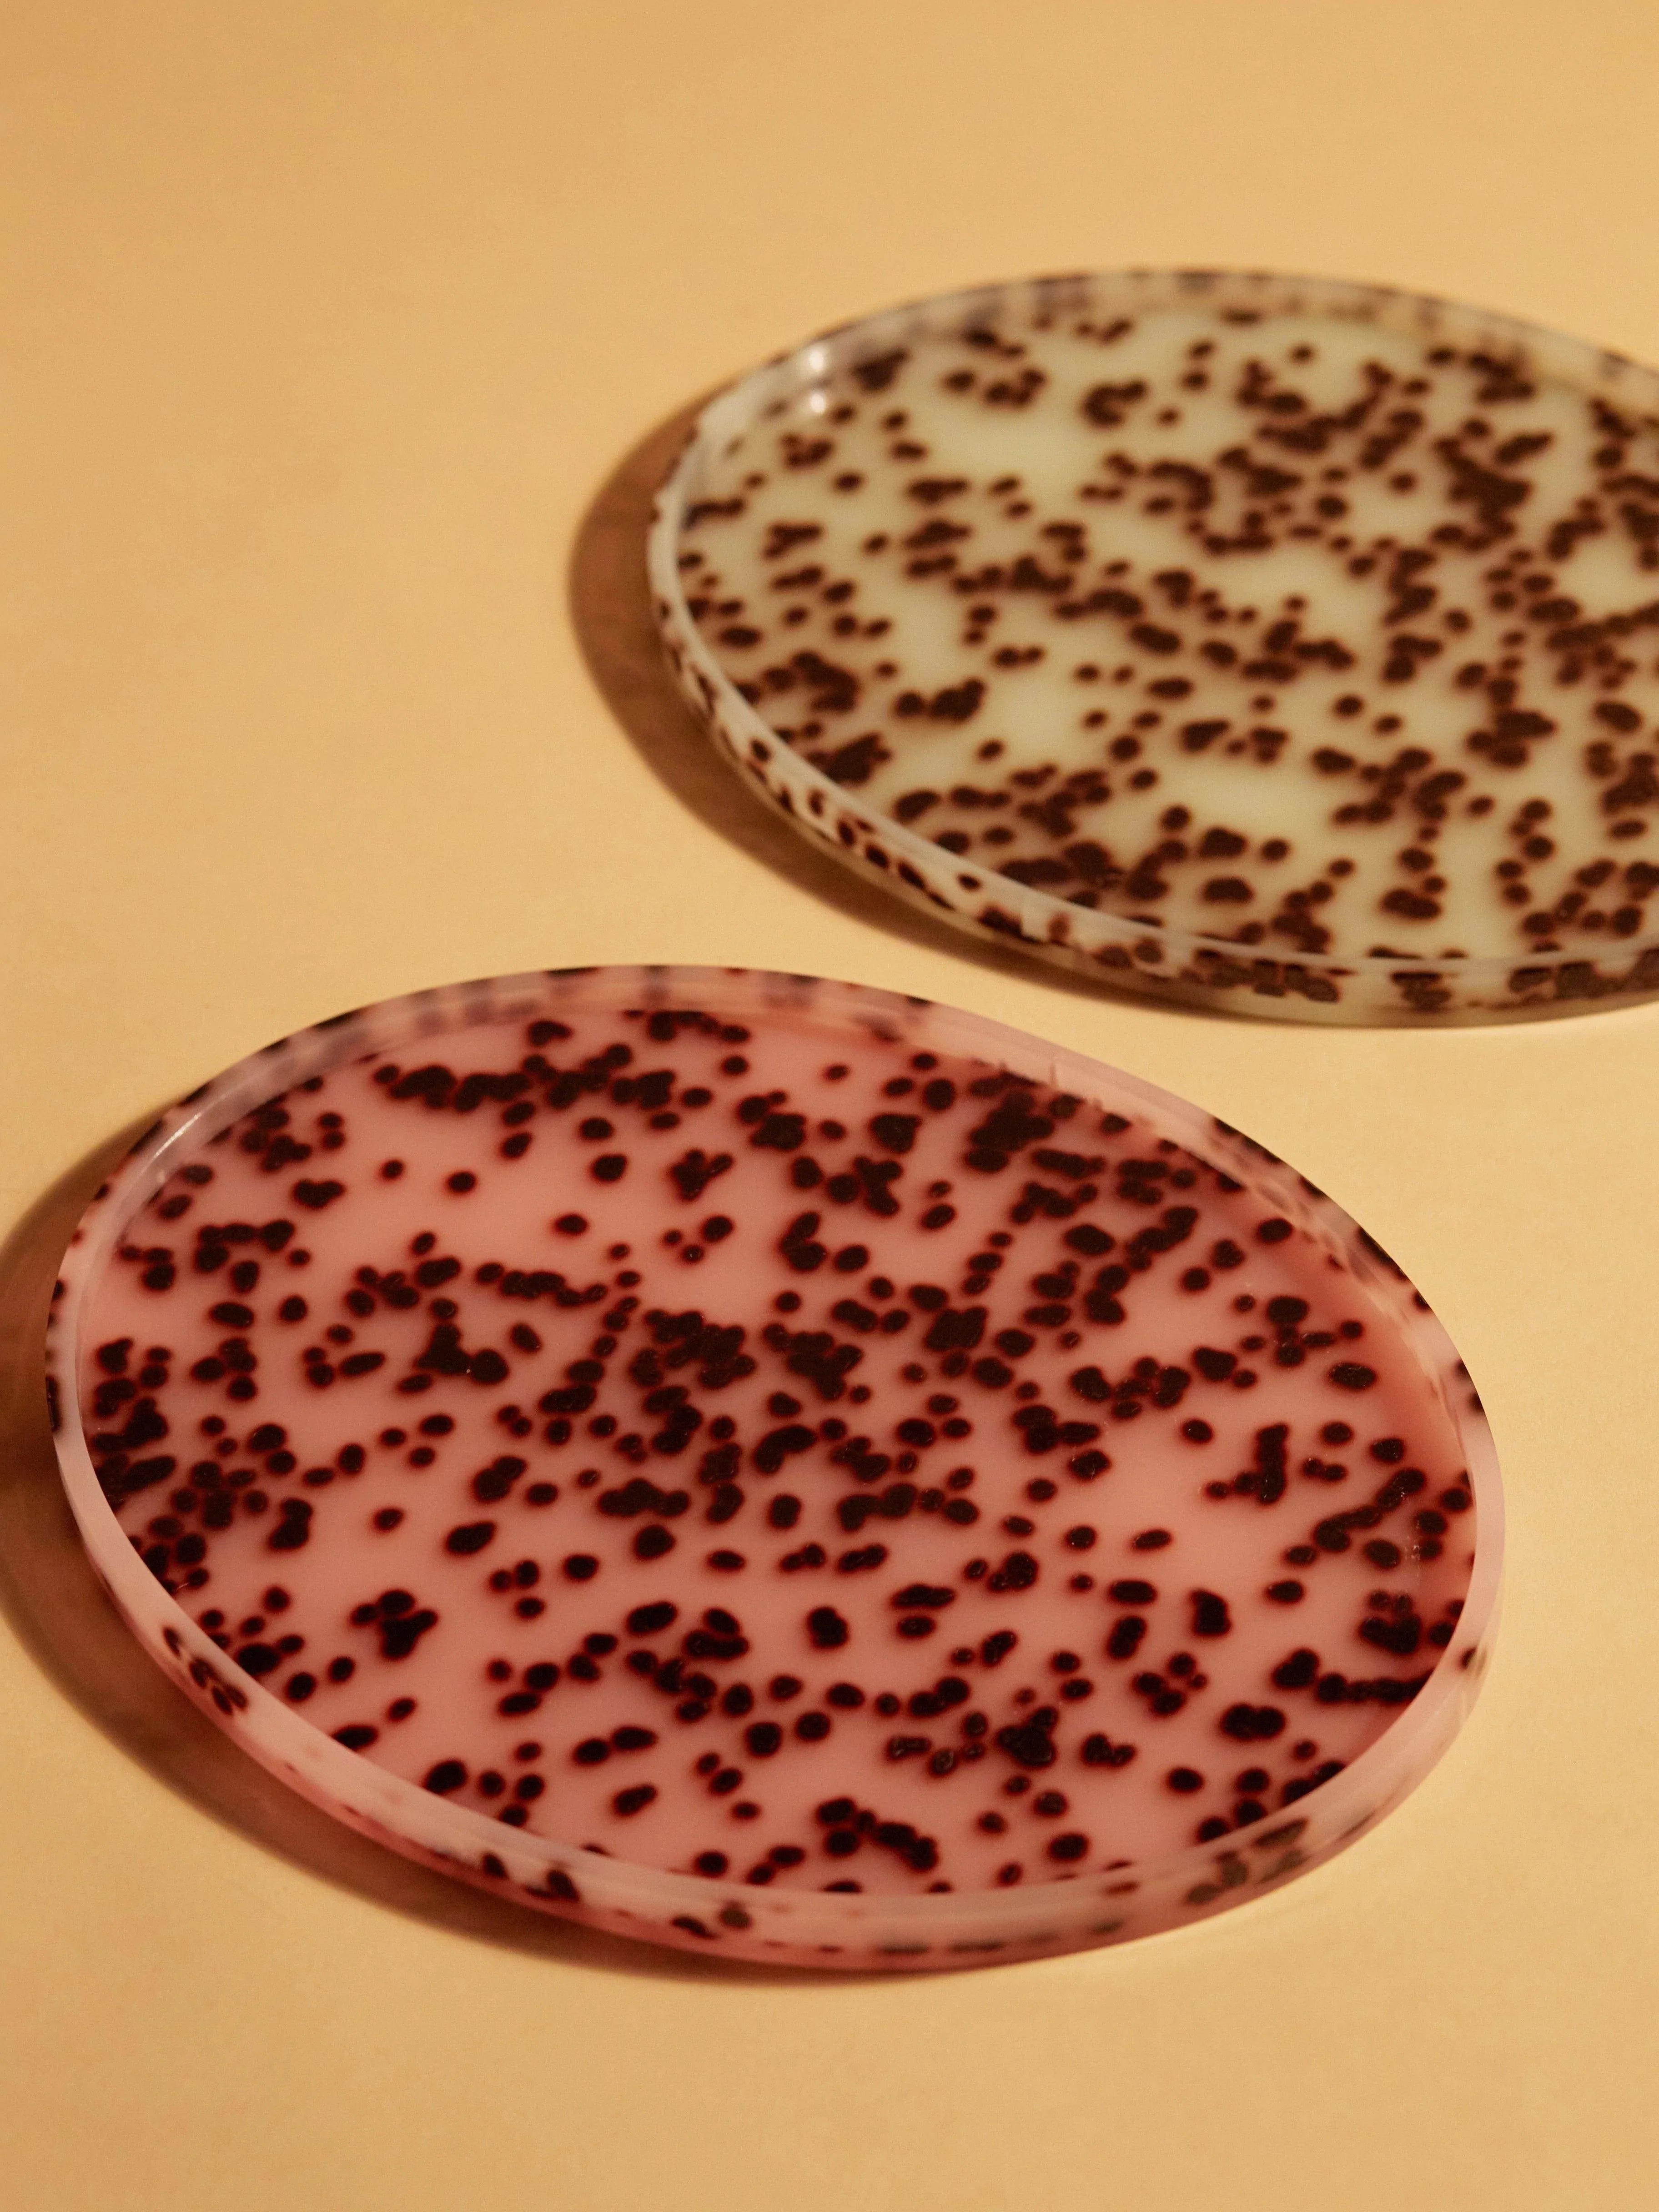
Oval Tray Turquoise Spot - Reliquia Jewellery

-
Maisie Clips in Pink and Clear -
Squared Scrunchie Blue -
Phoebe Clip Clear -
San Sebastian Scented Candle -
Cindy Scrunchie in Tie Dye Yellow -
Yoko Clip in Purple Haze -
Oval Tray Pink Spots -
Coaster Set Zebra -
Oval Tray Turquoise Spot -
Oval Tray White -
Oval Tray Brown Marble -
Oval Tray Zebra -
Oval Tray Plum -
Rectangle Tray Zebra -
Rectangle Tray Brown Marble -
Rectangle Tray Plum -
Rectangle Tray Turquoise Spot -
Rectangle Tray Black and White -
Top That! Hoops Silver -
Oval Tray Black and White -
Prince Clip in Brown Haze -
Coro Cult Set in Teal -
Coro Cult Set in Cobalt -
Coro Cult Set in Charcoal